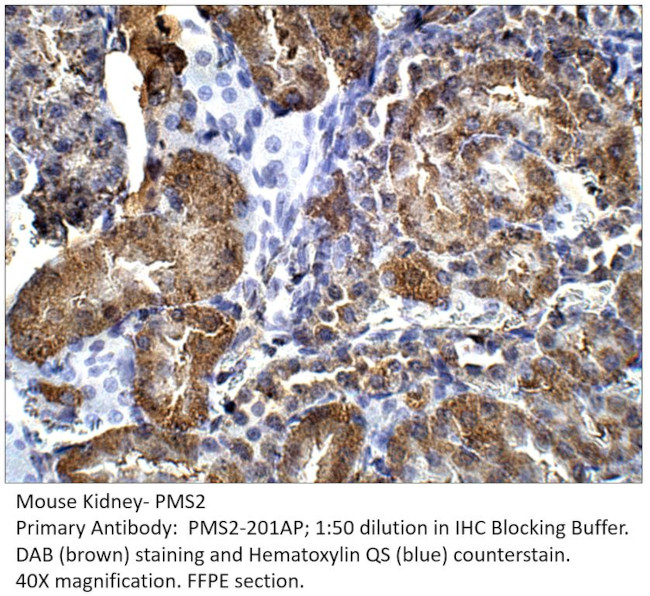
PMS2 Antibody in Immunohistochemistry (IHC)

Search
Fabgennix
PMS2 Polyclonal Antibody
{{$productOrderCtrl.translations['antibody.pdp.commerceCard.promotion.promotions']}}
{{$productOrderCtrl.translations['antibody.pdp.commerceCard.promotion.viewpromo']}}
{{$productOrderCtrl.translations['antibody.pdp.commerceCard.promotion.promocode']}}: {{promo.promoCode}} {{promo.promoTitle}} {{promo.promoDescription}}. {{$productOrderCtrl.translations['antibody.pdp.commerceCard.promotion.learnmore']}}
产品信息
PMS2-201AP
种属反应
宿主/亚型
分类
类型
抗原
偶联物
形式
浓度
纯化类型
保存液
内含物
保存条件
运输条件
靶标信息
PMS1 protein homologue 2 (PMS2) is a DNA mismatch repair protein. Defects in PMS2 are a cause of hereditary non-polyposis cancer (HNPCC). Human PMS2 is an amino acid protein of 862 amino acids.
仅用于科研。不用于诊断过程。未经明确授权不得转售。
篇参考文献 (0)
生物信息学
蛋白别名: DNA mismatch repair protein PMS2; H_DJ0042M02.9; Mismatch repair endonuclease PMS2; PMS1 homolog 2, mismatch repair protein; PMS1 protein homolog 2; PMS2 postmeiotic segregation increased 2; similar to S. cerevisiae PMS1 Swiss-Prot Accession Number P14242, S. cerevisiae MLH1 GenBank Accession Number U07187, E. coli MUTL Swiss-Prot Accession Number P23367, Salmonella typhimurium MUTL Swiss-Prot Accession Number P14161, Streptococcus pneumoniae ; unnamed protein product
基因别名: AW555130; HNPCC4; LYNCH4; MLH4; MMRCS4; PMS-2; PMS2; PMS2CL; PMSL2
UniProt ID: (Human) P54278, (Mouse) P54279
Entrez Gene ID: (Human) 5395, (Rat) 288479, (Mouse) 18861